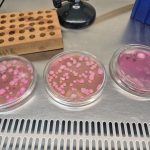

A Polícia Rodoviária Federal apreendeu nesta terça-feira (9) 17 kg de skunk na Rodovia Fernão Dias, em Três Corações (MG). A droga estava em um carro e seria entregue em Belo Horizonte (MG). O motorista de 24 anos foi preso.
De acordo com a PRF, a apreensão aconteceu durante uma fiscalização de combate à criminalidade, na altura do km 758. Ao abordar o carro conduzido pelo motorista, os policiais perceberam que ele estava nervoso e inquieto.
Além disso, os agentes da PRF notaram um forte odor de maconha dentro do veículo. Os policiais localizaram 34 pacotes de skunk nas laterais do veículo e no encosto do banco traseiro, totalizando 17 kg do entorpecente.
Segundo a PRF, o skunk é um tipo mais potente de maconha. Os policiais informaram que a droga vinha de Itaquiraí (MS) e tinha como destino Belo Horizonte (MG).
O motorista do carro foi preso por tráfico de drogas. Ele foi encaminhado para a Polícia Judiciária de Três Corações (MG) para as providências legais cabíveis.